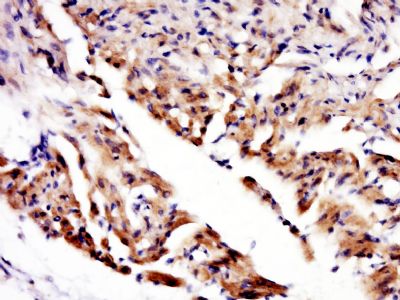
产品细节图片4

万千商家帮你免费找货
0 人在求购买到急需产品
- 详细信息
- 询价记录
- 文献和实验
- 技术资料
- 免疫原:
KLH conjugated
- 亚型:
IgG
- 形态:
冻干粉
- 保存条件:
Store at -20 °C for one year
- 克隆性:
多克隆
- 标记物:
见说明书
- 适应物种:
见说明书
- 宿主:
Rabbit
- 应用范围:
WB=1:500-2000 ELISA=1:500-1000 IHC-P=1:400-800 IHC-F=1:400-800 IF=1:100-500
- 浓度:
1mg/ml
- 靶点:
见说明书
- 抗体英文名:
CEA
- 抗体名:
癌胚抗原免疫组化荧光抗体
- 规格:
100ul
中文名称癌胚抗原抗体
别 名Carcinoembryonic antigen; Carcinoembryonic antigen related cell adhesion molecule 5; Carcinoembryonic antigen-related cell adhesion molecule 5; CD66e; CD66e; CD66e antigen; CEA; CEA; CEACAM5; CEAM5_HUMAN; DKFZp781M2392; Meconium antigen 100; OTTHUMP00000199032; OTTHUMP00000199033; OTTHUMP00000199034.
规格100ul 200ul
研究领域肿瘤 免疫学 干细胞 肿瘤细胞生物标志物
抗体来源Rabbit
克隆类型Polyclonal
交叉反应 Human, Rat,
产品应用WB=1:500-2000 ELISA=1:500-1000 IHC-P=1:400-800 IHC-F=1:400-800 Flow-Cyt=0.2μg/Test IF=1:100-500 (石蜡切片需做抗原修复)
not yet tested in other applications.
optimal dilutions/concentrations should be determined by the end user.
分 子 量71kDa
细胞定位细胞膜
性 状Lyophilized or Liquid
浓 度1mg/ml
免 疫 原KLH conjugated synthetic peptide derived from human CEA N-terminus:51-120/349
亚 型IgG
纯化方法affinity purified by Protein A
储 存 液0.01M TBS(pH7.4) with 1% BSA, 0.03% Proclin300 and 50% Glycerol.
保存条件Store at -20 °C for one year. Avoid repeated freeze/thaw cycles. The lyophilized antibody is stable at room temperature for at least one month and for greater than a year when kept at -20°C. When reconstituted in sterile pH 7.4 0.01M PBS or diluent of antibody the antibody is stable for at least two weeks at 2-4 °C.
PubMedPubMed
产品介绍background:
CEA-related cell adhesion molecules (CEACAM) belong to the carcinoembryonic antigen (CEA) family. It consists of seven CEACAM (CEACAM 1, CEACAM 3-CEACAM 8) and 11 pregnancy-specific glyco-protein (PSG 1-PSG 11) members. The CEA family proteins belong to the immunoglobulin (Ig) superfamily and are composed of one Ig variable-like (IgV) and a varying number (0-6) of Ig constant-like (IgC) domains. CEACAM molecules are membrane-bound either via a transmembrane domain or a glycosyl phosphatidyl inositol (GPI) anchor. CEACAM molecules are differentially expressed in epithelial cells or in leucocytes. Over-expression of CEA/ CEACAM 5 in tumors of epithelial origin is the basis of its wide-spread use as a tumor marker. The function of CEACAM family members varies widely: they function as cell adhesion molecules, tumor suppressors, regulators of lymphocyte and dendritic cell activation, receptors of Neisseria species and other bacteria.
Function:
Cell surface glycoprotein that plays a role in cell adhesion and in intracellular signaling. Receptor for E.coli Dr adhesins.
Subunit:
Homodimer. Binding of E.coli Dr adhesins leads to dissociation of the homodimer.
Subcellular Location:
Cell membrane; Lipid-anchor, GPI-anchor
Tissue Specificity:
Found in adenocarcinomas of endodermally derived digestive system epithelium and fetal colon.
Post-translational modifications:
Complex immunoreactive glycoprotein with a MW of 180 kDa comprising 60% carbohydrate.
Similarity:
Belongs to the immunoglobulin superfamily. CEA family.
Contains 7 Ig-like (immunoglobulin-like) domains.
SWISS:
P40199
Gene ID:
4680
Database links:
Entrez Gene: 4680 Human
Entrez Gene: 100125369 Rat
Omim: 163980 Human
SwissProt: P40199 Human
Unigene: 466814 Human
Unigene: 122781 Rat
Important Note:
This product as supplied is intended for research use only, not for use in human, therapeutic or diagnostic applications.
CEA是一种胚胎性抗原,主要存在于胎儿消化道上皮组织,胰腺和肝癌中。CEA广泛存在各种上皮性肿瘤,尤其是胃肠道恶性肿瘤,CEA分布阳性类型与肿瘤的恶性度有关。CEA与EMA一样可作为上皮性恶性肿瘤的重要标记。
风险提示:丁香通仅作为第三方平台,为商家信息发布提供平台空间。用户咨询产品时请注意保护个人信息及财产安全,合理判断,谨慎选购商品,商家和用户对交易行为负责。对于医疗器械类产品,请先查证核实企业经营资质和医疗器械产品注册证情况。
- 作者
- 内容
- 询问日期
 文献和实验
文献和实验【摘要】对自制时间分辨免疫荧光法定量检测癌胚抗原(CEA)试剂盒进行临床应用研究,为该试剂盒临床应用及临床疗效评价提供科学依据。 方法 收集血清标本326份,用自制试剂盒按试剂盒操作说明书对血样进行测定,并以化学发光法(Roche)为对照方法,WALLAC公司的CEA时间分辨免疫测定药盒(AutoDELFATM hCEA)作为复核试验,获取相关目标实验数据,并计算得“真实性”和“可靠性”等统计学数据。 结果 以化学发光法为对照试验,其阳性符合率为95.83%,阴性符合率为98.73%,检验
检测方法:ELISA、RIA、荧光偏振免疫测定、免疫发光技术、自动化免疫分析等。 参考值:正常情况下,血清CEA 临床意义(腺癌检测指标) (1)可作为成人结肠癌辅助诊断的重要项目,还有助于疗效评价和预后监测。 (2)作为胰腺癌、乳腺癌诊断的参考指标。医学教育|网搜集整理
癌胚抗原检测: 检测方法:ELISA、RIA、荧光偏振免疫测定、免疫发光技术、自动化免疫分析等。 参考值:正常情况下,血清CEA 临床意义(腺癌检测指标): (1)可作为成人结肠癌辅助诊断的重要项目,还有助于疗效评价和预后监测。 (2)作为胰腺癌、乳腺癌诊断的参考指标医学教育|网搜集整理。